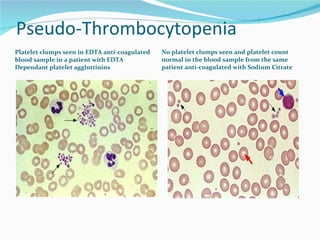
Pseudo-Thrombocytopenia Platelet clumps seen in EDTA anti-coagulated blood sample in a patient with EDTA Dependant platelet aggluttinins No platelet clumps seen and platelet count normal in the blood sample from the same patient anti-coagulated with Sodium Citrate

This document outlines essential concepts in hematology, particularly focusing on thrombocytopenia, its definitions, causes, and clinical implications. It details the role of thrombopoietin in platelet production, the significance of platelet counts, and various classifications of thrombocytopenia based on underlying mechanisms. The document also addresses diagnostic approaches and treatment options for conditions like thrombosis and thrombotic thrombocytopenic purpura (TTP).

![1. Pivetti S, et al. Br J Haematol. 1996;95:204-211. 2. Pawlotsky JM, et al. J Hepatol. 1995;23:635-639. 3. Sakuraya M, et al. Eur J. Haematol. 2002;68:49-53. 4. García-Suárez J, et al. Br J Haematol. 2000;110:98-103. 5. Rajan SK, et al. Br J Haematol. 2005;129:818-824. Study N Platelet Threshold, x 10 9 /L HCV Positive, n (%) Pivetti et al [1] 33 < 100 12 (36) Pawlotsky et al [2] 139 < 25 14 (10) Sakuraya et al [3] 79 < 10 11 (14) García-Suárez et al [4] 51 < 100 13 (23) Rajan et al [5] 250 < 100 76 (30)](https://image.slidesharecdn.com/thrombocytopenia1-111216174418-phpapp01/85/Thrombocytopenia-38-320.jpg)

































![Therapeutic interventions: prednisone, anti-D, splenectomy, or HAART Incidence of ITP in HIV *Platelets < 50 x 10 9 /L 1. Murphy MF, et al. Br J Haematol. 1987;66:337-340. 2. Kaslow RA, et al. Ann Intern Med. 1987;107:474-480. 3. Rossi G, et al. AIDS Res Hum Retroviruses. 1990;6:261-269. 4. Peltier JY, et al. AIDS. 1991;5:381-384. 5. Mientjes GH, et al. Br J Haematol. 1992;82:615-619. 6. Sloand EM, et al. Eur J Haematol. 1992;48:168-172. 7. Sullivan PS, et al. J Acquir Immune Defic Syndr Hum Retrovirol. 1997;14:374-379. Study N ITP, n (%) Murphy et al [1] 105 11 (10.5) Kaslow et al [2] 1611 108 (6.7) Rossi et al [3] 657 72 (10.9) Peltier et al [4] 435 23 (5.5) Mientjes et al [5] 285 67 (23.5) Sloand et al [6] 1004 110 (11) Sullivan et al [7] 30,214 1106 (3.7)* Total 34,311 1497 (4.4)](https://image.slidesharecdn.com/thrombocytopenia1-111216174418-phpapp01/85/Thrombocytopenia-72-320.jpg)






![This research was originally published in Blood. Provan D, et al. Blood. 2009;[Epub ahead of print]. © the American Society of Hematology. Treatment Strategy Response Rate Time to Response Response Duration Cortico-steroids Prednisone: 0.5-2mg/kg x 2-4 weeks 70-80% respond initially Several days to several weeks Uncertain Me-Pred: 30mg/kg/d for 7 days ≤ 95% respond initially Few days 23% have > 50x10 9 /L at 39 months Immune Globulin IVIg: 0.4g/kg/d x 5d, 1g/kg/d x 1-2d ≥ 80% respond initially 1-2 days 3-4 weeks, months in some Anti-D: 50–75 µg/kg 50-80% (dose dependent) 1-5 days (dose dependent) Typically 3–4 weeks, months in some](https://image.slidesharecdn.com/thrombocytopenia1-111216174418-phpapp01/85/Thrombocytopenia-79-320.jpg)


![Management of Adult ITP: Rituximab Since previous consensus guidelines [1,2] were published, several studies on the use of anti-CD20 therapy have been published Approximately 60% of patients respond to rituximab treatment and approximately 45% have a CR [3] ; long-term responses (> 4 yrs) occur in 20% of patients The optimal dose of rituximab for ITP treatment is unknown and cases of multifocal leukoencephalopathy have been reported, particularly in patients who have been previously heavily immunosuppressed [4] The drug may be more effective if used earlier in the course of ITP ( may save splenectomy) 1. George JN, et al. Blood. 1996;88:3-40. 2. British Committee for Standards in Haematology General Haematology Task Force. Br J Haematol. 2003;120:574-596. 3. Arnold DM, et al. Ann Intern Med. 2007;146:25-33. 4. Provan D, et al. Blood. 2009;[Epub ahead of print].](https://image.slidesharecdn.com/thrombocytopenia1-111216174418-phpapp01/85/Thrombocytopenia-82-320.jpg)
![Management of Adult ITP: Thrombopoietin Receptor Agonists Recent placebo-controlled randomized clinical trials have demonstrated the utility of 2 thrombopoietin receptor agonists, romiplostim and eltrombopag, in increasing platelet counts in patients refractory to first- or second-line therapy [1,2] These are maintenance agents that support a safe platelet count but have no effect on the underlying ITP pathophysiology However, the ability of these agents to increase platelet counts in refractory postsplenectomy patients, allowing for reduction or cessation of immunosuppressive agents, may make them the treatment of choice in this patient population. FDA approved for Chronic Refractory ITP. 1. Kuter DJ, et al. Lancet. 2008;371:395-403. 2. Bussel JB, et al. Lancet. 2009;373:641-648.](https://image.slidesharecdn.com/thrombocytopenia1-111216174418-phpapp01/85/Thrombocytopenia-83-320.jpg)

![New Recommendations for ITP Evaluation Bone marrow aspirate and biopsy with flow studies for patients older than 60 yrs [1] Why : In addition to excluding underlying myelodysplasia, flow studies may be helpful in identifying patients with an ITP secondary to CLL [1] Screen for HIV and HCV antibodies and assess H. pylori infection by urea breath or stool antigen test [1] Why : 4% to 30% of patients, depending on the background infection rates in the local population, may have ITP secondary to HIV, HCV, or H. pylori ; treatment of the primary chronic infection can result in an increase in the platelet count [2] 1. Provan D, et al. Blood. 2009;[Epub ahead of print]. 2. Cines DB, et al. Blood. 2009;113:6511-6521.](https://image.slidesharecdn.com/thrombocytopenia1-111216174418-phpapp01/85/Thrombocytopenia-85-320.jpg)
![New Recommendations for ITP Evaluation Quantitative immunoglobulins [1] Why : This test should be done before patients receive intravenous immunoglobulins; this will reveal patients with CVID or IgA deficiency Direct antiglobulin test [1] Why : A positive DAT was reported in 22% of 205 patients with ITP [2] ; important if patient has anemia and/or a high reticulocyte count Blood group Rh(D) typing [1] Why : Important if treatment with anti-RhD immunoglobulin is being considered; should be done in conjunction with DAT, since a positive DAT may modify a decision to use anti-D therapy 1. Provan D, et al. Blood. 2009;[Epub ahead of print]. 2. Aledort LM, et al. Am J Hematol. 2004;76:204-213.](https://image.slidesharecdn.com/thrombocytopenia1-111216174418-phpapp01/85/Thrombocytopenia-86-320.jpg)
















































